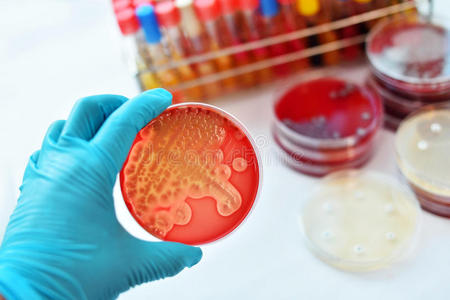
培养涂抹,念珠菌病,阴道炎,衣原体革兰阴性菌细菌的主要形式性传播

衣原体培养

衣原体课件
图片尺寸814x1128
衣原体
图片尺寸1080x1439
培养特性;抗原结构;致病性;免疫性;主要病原性衣原体;微生物检查;防治
图片尺寸854x1560
衣原体感染怎么治疗衣原体感染龟头会有什么症状
图片尺寸1280x854![起到作用,想换个医生,求推荐[合十r]#中药 #中医中药 #医生 #衣原体](https://i.ecywang.com/upload/1/img1.baidu.com/it/u=2622015289,2237293698&fm=253&fmt=auto&app=138&f=JPEG?w=500&h=667)
起到作用,想换个医生,求推荐[合十r]#中药 #中医中药 #医生 #衣原体
图片尺寸1080x1440
性出血#妇科知识 ,#妇科 看了妇科,做了宫颈筛查还有支原体衣原体
图片尺寸828x1104
衣原体肺炎一种常见但容易忽视的社区获得性肺炎
图片尺寸655x893
知道怎么看支原体和衣原体的培养检验单不?
图片尺寸650x683
一种流产衣原体的细胞培养方法及应用与流程
图片尺寸1000x393
男生也需要检查衣原体支原体噢
图片尺寸1080x790
沙眼衣原体,性传播疾病,完全可以治愈的,没有明显的症状或体征
图片尺寸640x481
口交与沙眼衣原体感染 - 好大夫在线
图片尺寸1200x794
什么是衣原体和支原体感染-精准抗艾-互联网艾滋病性病预防诊疗平台
图片尺寸3150x2595
什么情况下做支原体衣原体检查?
图片尺寸800x450
开放郑州 枢纽之城 活力之城
图片尺寸500x333
培养涂抹,念珠菌病,阴道炎,衣原体革兰阴性菌细菌的主要形式性传播
图片尺寸450x300
微生物图谱之支原体衣原体
图片尺寸446x367
培养涂抹,念珠菌病,阴道炎,衣原体革兰阴性菌细菌的主要形式性传播
图片尺寸301x300
lemmaid="2259772">无菌性前列腺炎 /a>,其发病原因主要包括衣原体
图片尺寸576x380
衣原体培养有解脲有人型支原体生长严重吗?会导致什么后果!
图片尺寸768x1024